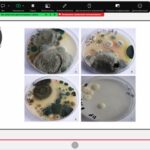

Студенти 2 та 3 курсів освітньо-професійної програми «Зберігання, консервування та переробка м’яса» заглибилися у тонкощі професії під час онлайн-лекції на платформі Zoom.
Вивчали одну з найважливіших тем «Мікробіології м’яса» — Санітарно-показові мікроорганізми.
Говорили як за допомогою мікробіологічних маркерів визначити якість сировини; які мікроорганізми сигналізують про порушення гігієни на виробництві; чому контроль безпечності — це фундамент довіри споживача.
Отримані знання допоможуть майбутнім фахівцям забезпечувати належний рівень гігієни та безпечності продукції на підприємствах м’ясної галузі.